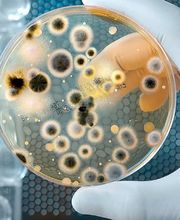
My Safe Air  Logo

My Safe Air
0.0(0 Bewertungen)
Am Pfarrgarten 4 , 68782 Brühl
+491736628993 (Mobil)
Info
My Safe Air Wir sorgen für frische und gesunde Luft Wir sind spezialisiert auf die hygienische Reinigung von Lüftung/Klimaanlagen. Dies beinhaltet die Reinigung der Luftauslässe,Verrohrung,Kanäle und aller Lüftungsgeräten, eingeschlossen aller Kühl-und Heizregister. Denn diese sind maßgeblich für den Wirkungsgrad bzw. die Betriebskosten der Anlage verantwortlich. Alles nach VDI 6022
Medien

Map
Am Pfarrgarten 4 , 68782 Brühl
Bewertungen
Nicht verifizierte Bewertungen0.0
(0 Bewertungen)


